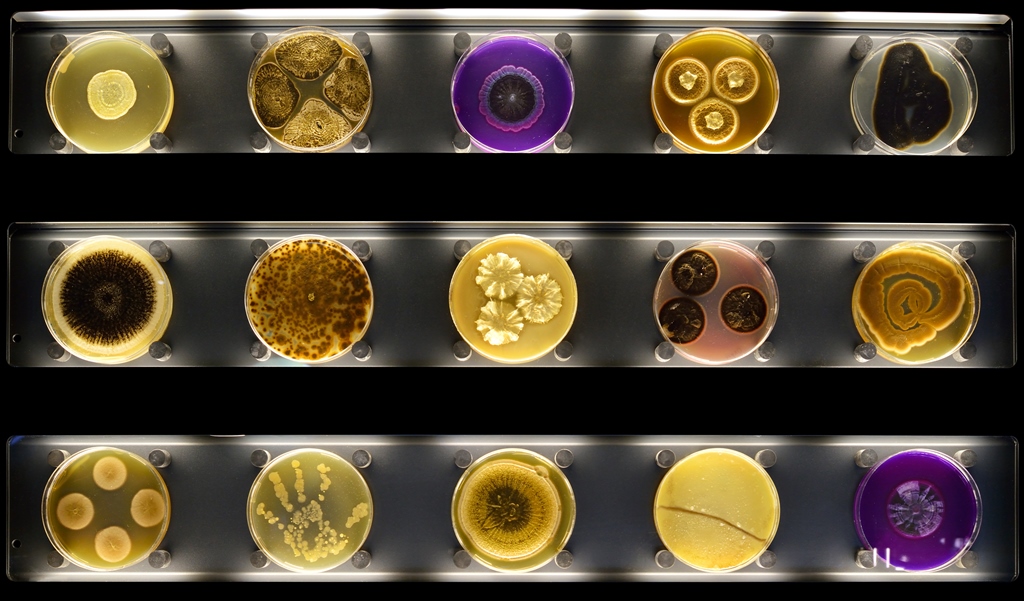

Maurice de Jong
Redacteur

Redacteur

Het is altijd weer een kleine schok als je na een aantal jaar terugkomt in een land. Zo ook toen ik vorige maand een supermarkt binnenstapte in Zuid-Afrika

Het lijkt slechts een kwestie van tijd totdat verplichte herkomstetikettering voor producten met vlees als ingrediënt haar opwachting maakt. Het Europees Parlement gaf afgelopen week het groene licht hiervoor. De Europese Commissie zal dit duidelijke politieke signaal niet snel naast zich neerleggen, verwacht de Algemene Kokswaren en Snackproducenten Vereniging (AKSV).

Veel voedingsbedrijven doen er alles aan om hun keten te verduurzamen. Op het Food Event op 2 april een workshop hoe je dit precies aanpakt. Lucas Simons beantwoordt drie vragen over de transformatie van een verantwoorde keten.

Ondanks de rode kaart die Foppen kreeg van de Nederlandse Voedsel en Waren Autoriteit (NVWA) , houdt supermarktketen Albert Heijn het volste vertrouwen in zijn belangrijke visleverancier, zegt een woordvoerder tegen vmt.nl. "Code rood zegt niet dat het voedsel niet veilig is."
Micropia wil de wereld van micro-organismen zichtbaar en toegankelijk maken voor het grote publiek. Dit museum waar levenden microben te zien zijn, maakt onderdeel uit van de Amsterdamse dierentuin Artis en opende afgelopen najaar zijn deuren. Het biedt een mooi podium voor de voedingsindustrie.

Een jaar eerder dan gepland behaalt Ferrero, producent van Nutella, zijn doelstelling om alleen nog maar 100% gesegregeerde palmolie te gebruiken. Deze is in overeenstemming met de principes van de Ronde Tafel voor Duurzame Palmolie (RSPO) van de gescheiden toeleveringsketen.

Een olifant, tijger en giraffe; wie kent deze dieren niet? Minder aaibaar en zichtbaar is de wereld van de microben. Er zijn er ontelbaar veel en ze zijn alom vertegenwoordigd. Micropia in Amsterdam toont dit kleinste leven op aarde om een breed publiek te enthousiasmeren voor microben en hun toepassingen, onder meer in de voedingsindustrie.

Niet-gouvernementele organisaties (ngo's) beoordelen voedingsbedrijven kritisch op hun duurzaamheidsprestaties. Naast een luis in de pels werken ze ook samen met de fabrikanten om verduurzaming aan te jagen. Wat zijn volgens hen de thema's voor 2015 en hoe presteert de voedingsindustrie?

Bierbrouwer Bavaria gebruikt geen chemicaliën bij het beheer van haar bedrijventerrein in Lieshout. Het bedrijf speelt hiermee in op wetgeving die volgend jaar ingaat.

Momenteel telt Nederland 2,8 miljoen mensen tussen de 60 en 75 jaar. Dat aantal zal blijven toenemen. Toch zijn er niet veel voedingsmiddelen bestemd voor deze groep babyboomers. Zij hebben echter wel behoefte aan dergelijke producten.